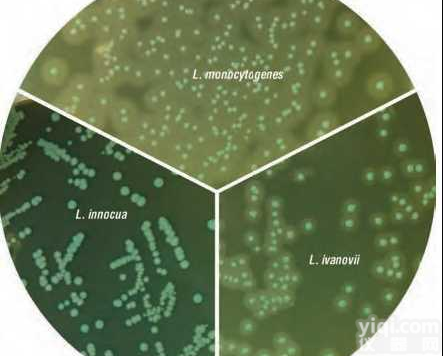
单增<em>李斯特</em>菌显色鉴别<em>琼脂</em>
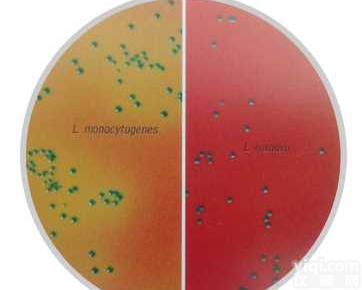
<em>李斯特</em>菌显色<em>琼脂</em>（改良型）

ChromoCult®李斯特 选择性琼脂添加剂(冻干粉)厂家,价格
- 型号:ChromoCult®李斯特 选择性琼脂添加剂(冻干粉)
- 供应商:上海将来实验设备有限公司
- 供应商报价:电议
- 标签:ChromoCult®李斯特 选择性琼脂添加剂(冻干粉)厂家,价格,供应ChromoCult®李斯特 选择性琼脂添加剂(冻干粉)厂家,价格,上海将来实验设备有限公司
上海将来实验设备有限公司供应ChromoCult®李斯特 选择性琼脂添加剂(冻干粉)厂家,价格
本公司向您保证所售产品均为,并开具正规普通或增值税发票。凭发票和购买货品,可享受退货、换货、维修等产品保证服务。欢迎来电咨询 !
其他相关产品 www.jonln.com
低温冷却液循环泵
恒温干燥箱|鼓风干燥箱价格
旋转蒸发器价格
现货报价日本SMC5通电磁阀VS4220-022.VS4220-022P参数型号规格说明
细菌浊度计价格|规格
现货报价日本SMC油雾器AL402-06,AL404-02-X201图片资料说明
现货报价日本SMC减压阀AR30-02H.AR30-03-YB图片资料说明
热空气消毒箱-6
MP516溶氧仪,测量仪,监测仪价格
电子防潮箱
现货报价日本SMC带导杆薄型气缸MGPM32-75.MGPM32-75-RL参数型号规格说
静水力学天平(5000g/0.01g)
蜂蜜快速检测仪
干式恒温器UMB-12
MI3200 10KV大功率(5mA)高压兆欧表
数字式粘度计(DV-1+Pro)
MP525 溶解氧仪,精密pH计厂家
WHD-8数显电火花检测仪
方块制冰机
智能片剂硬度仪-2
现货报价日本SMC流体控制用阀VNB414A-2-4GB.VNB414A-2-4T
转动式麦氏真空计PM-3
有害废物过滤系统
现货快速报价日本SMC过滤减压阀AW40-F04DH.AW40-F04DG图片资料说明
便携式污泥浓度计-4
冰排0.4L价格|规格
电热鼓风干燥箱|鼓风干燥箱价格
TQ-1000双气路大气采样器
RH KT/C 数显型加热磁力搅拌器(安全温度控制)
可编程一体化箱式电炉
连续变倍体视显微镜